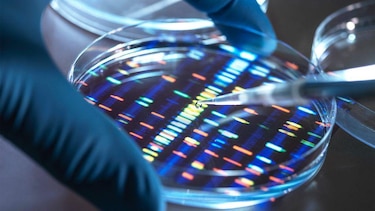
Qué son los ‘cristales de memoria’ que desafían las leyes de la física y prometen solucionar el problema del almacenamiento masivo de datos

Laurie Clarke
Durante una visita a Japón en 1999, el investigador Peter Kazansky se encontró con un misterioso fenómeno físico que ahora cree que contiene la clave para el futuro del almacenamiento de datos.
En el laboratorio de optoelectrónica de la Universidad de Kioto, los científicos experimentaban con escribir sobre vidrio utilizando láseres ultrarrápidos de femtosegundos, que emiten un pulso de luz cada cuatrillonésima de segundo.
Pero notaron algo inusual en cómo la luz viajaba a través del vidrio tratado con láser. La dispersión de Rayleigh es un efecto bien establecido que describe cómo la luz blanca rebota en partículas pequeñas en todas direcciones (lo que explica, entre otras cosas, por qué el cielo se ve azul). Pero en este caso, la luz no rebotaba como se esperaba.
“Fue difícil de explicar”, afirma Kazansky, profesor de optoelectrónica en la Universidad de Southampton (Reino Unido), quien colaboraba con los investigadores de la Universidad de Kioto. “Vimos cómo la luz se dispersaba de una manera que parecía desafiar las leyes de la física”.
La observación desconcertante acabó provocando “un auténtico momento eureka”, dice Kazansky. Los investigadores descubrieron nanostructuras ocultas dentro del vidrio de sílice, creadas por “microexplosiones” generadas por los láseres de femtosegundos.
Imagina sostener un grueso trozo de cristal a contraluz y ver cómo la luz rebota en muchas direcciones distintas. Con la técnica del láser, los investigadores de Kioto habían creado accidentalmente pequeños orificios con esa misma propiedad.
Unas mil veces más pequeños que el grosor de un cabello humano, estos “remolinos” de luz son tan diminutos que resultan imperceptibles para el ojo humano. Pero pronto quedó claro para los científicos que tenían un potencial transformador. “Esta fue la primera prueba de que podíamos usar la luz para imprimir patrones complejos dentro de materiales transparentes a una escala menor que la longitud de onda de la luz”, afirma Kazansky.
Ahora, 27 años después, espera que aquel descubrimiento pueda ayudar a resolver uno de los problemas más difíciles de nuestra era de la información: el almacenamiento masivo de datos.
Nuestro problema con los datos

En la era de Internet, la inteligencia artificial, los hogares inteligentes y el capitalismo de vigilancia, hay algo que simplemente no dejamos de producir: datos.
Según la empresa de análisis IDC, para 2028 generaremos colectivamente 394 billones de zettabytes de información cada año (un zettabyte equivale a un billón de gigabytes). Cada vez que hacemos cualquier cosa en Internet -ver un video en YouTube, enviar un correo electrónico, hacerle una pregunta a un chatbot de IA- cadenas de puntos de datos salen disparadas hacia el ciberespacio.
La idea de que los datos “pesan poco” es engañosa: aunque imaginemos la información viajando de forma etérea por cables submarinos o flotando suavemente en “la nube”, en realidad requiere recursos físicos enormes, cuya demanda ya resulta insaciable.
Los centros de datos consumen cantidades masivas de electricidad, agua y materiales, y su crecimiento exponencial está obligando a buscar alternativas radicales.
Este dilema está impulsando soluciones novedosas, como la propuesta de Kazansky de grabar datos en vidrio mediante láseres. Otras opciones, como almacenar información en ADN, también están siendo exploradas por científicos y empresas como Microsoft.
Los datos se procesan y se alojan en centros de datos: estructuras gigantescas, casi alienígenas, repletas de filas de servidores de más de dos metros de altura, parpadeando sin descanso.
Estas cajas zumbantes de hardware y cables devoran energía, necesaria tanto para su capacidad de cómputo como para los enormes sistemas de refrigeración que evitan que se incendien. (Un centro de datos no es un lugar agradable para trabajar: caliente y ensordecedor, es adecuado solo para quienes pueden “soportar mucho dolor”, según una investigación de The New Yorker de 2025).
A escala global, los centros de datos representan alrededor del 1,5% de la demanda eléctrica mundial, pero se proyecta que su consumo se duplicará para 2030, momento en el que también podrían generar 2.500 millones de toneladas de emisiones de CO₂ equivalente, aproximadamente el 40% de todas las emisiones anuales de Estados Unidos.
El reciente auge de la IA generativa ha empeorado la situación, aumentando drásticamente la demanda de sistemas de computación de alto rendimiento que consumen cantidades colosales de energía y expulsan nubes intensas de calor.
La mayor parte de la energía que utilizan los centros de datos se gasta en los “datos calientes”: información que debe estar disponible al instante para un acceso rápido y actualizaciones frecuentes. Piensa en transferir dinero desde tu cuenta bancaria o en los documentos en línea que editas con regularidad.
Pero la mayoría de los datos del mundo no son de este tipo; hasta un 80% son en realidad “datos fríos”: información que nadie necesita de inmediato y que, cuando se requiere, las personas están dispuestas a esperar minutos o incluso días para obtenerla.
Esto incluye datos de cumplimiento, como registros financieros o rastros de auditoría que los bancos y otras corporaciones deben conservar indefinidamente. También entran en esta categoría las copias de seguridad de tus correos electrónicos o fotos antiguas, así como los datos archivados.
Almacenar estos datos plantea problemas. La mayor parte se guarda actualmente en discos duros dentro de centros de datos. Estos deben permanecer encendidos para que la información sea recuperable, lo que exige energía y sistemas de refrigeración.
Otra solución cada vez más popular es la cinta magnética, que se almacena en las propias instalaciones del centro de datos o en bibliotecas de cintas especializadas. Debe mantenerse a temperaturas de 16‑25 °C (61‑77 °F), lo que implica también un consumo energético para conservar sus condiciones ideales.
Además, necesita reemplazarse cada 10‑20 años debido a su degradación, momento en el cual la cinta antigua se desecha como residuo. El enorme aumento en la producción de datos ha impulsado una fuerte demanda de cinta magnética en los últimos años.
“Cristales de memoria”

Todo esto hace que la búsqueda de soluciones alternativas sea cada vez más urgente. Kazansky está adoptando un enfoque novedoso al problema. En los años posteriores a aquella primera revelación en la Universidad de Kioto, descubrió que los remolinos de diminutas perforaciones grabadas en el vidrio podían leerse de forma muy similar a los datos en las fibras ópticas.
Explica que este método codifica datos en cinco dimensiones utilizando la diferencia en la orientación y la intensidad de la luz combinadas con la ubicación de distintos “vóxeles” (es decir, píxeles tridimensionales individuales con coordenadas x, y, z).
“Al aprovechar estas propiedades de la luz, podemos almacenar datos en cinco dimensiones en lugar de las tres habituales, lo cual es la clave para lograr la alta densidad necesaria para un almacenamiento ‘eterno’”, afirma Kazansky.
La información se lee mediante un microscopio óptico especializado equipado con una cámara capaz de detectar tanto la intensidad como la polarización de la luz. “Como las nanoestructuras modifican la forma en que la luz viaja a través de ellas, usamos ópticas especiales para ‘ver’ esos cambios de polarización, que luego se decodifican nuevamente en datos digitales”, explica Kazansky.
En los “cristales de memoria” de Kazansky, se necesita energía únicamente para el proceso de escritura de datos, pero no se requiere energía adicional para mantenerlos, y el proceso de lectura tampoco es intensivo en consumo.
Pueden contener una cantidad vertiginosa de información en un área muy pequeña: teóricamente, hasta 360 terabytes (TB) -cada uno equivalente a 1.000 GB- en un disco de vidrio de 5 pulgadas (12,7 cm).
Y, según afirma, pueden durar esencialmente para siempre. Están hechos de vidrio de sílice fundido, conocido por su durabilidad y estabilidad térmica. La única precaución especial es mantenerlos dentro de un contenedor resistente, ya que, al estar hechos de vidrio, siguen siendo vulnerables a romperse de la manera tradicional.
Kazansky, junto con su hijo, fundó una empresa en 2024 para comercializar su idea y recientemente completó una ronda de financiación de US$4,5 millones. Afirma que SPhotonix ya está en conversaciones con empresas tecnológicas para estrenar algunos de sus prototipos en centros de datos durante los próximos años. Por ahora, sin embargo, señala que el objetivo sigue siendo “perfeccionar la tecnología para garantizar que sea lo suficientemente robusta” para estos usos.
Actualmente, la empresa puede alcanzar una velocidad de lectura de unos 30 MB por segundo, pero espera aumentar las velocidades de lectura y escritura hasta 500 MB por segundo en los próximos tres a cinco años, según Kazansky. (En comparación, las soluciones más recientes de almacenamiento en cinta magnética ofrecen hasta 400 MB por segundo).
“Nuestra meta es que recuperar datos… sea tan fluido como usar un disco duro moderno”, afirma.
Pero no todos creen que los cristales de memoria representen el futuro inmediato del almacenamiento de datos. Según Srinivasan Keshav, profesor de informática en la Universidad de Cambridge (Reino Unido), uno de los problemas es que la tecnología no es “compatible con la infraestructura existente”, lo que crea “enormes barreras de adopción”.
Kazansky no es el único que piensa en cómo afrontar la enorme acumulación de datos del siglo XXI. Mientras él ha encontrado respuestas en granos de arena, otros han recurrido al sustrato granular de toda la vida orgánica.
Datos en ADN
La idea de usar ADN como medio de almacenamiento fue propuesta por primera vez en 1964 por el físico soviético Mikhail Samoilovich Neiman, y las demostraciones realizadas desde la década de 1980 han confirmado su viabilidad.
Sus defensores afirman que ofrece una solución extraordinariamente eficiente y duradera. Un solo gramo de ADN podría almacenar teóricamente hasta 215 petabytes (PB) -cada uno equivalente a un millón de GB- de datos durante miles de años.
Transformar bytes en bases nucleotídicas resulta sorprendentemente sencillo. “Tomas tus datos digitales y los asignas a los componentes básicos del ADN”, explica Thomas Heinis, profesor de gestión de datos en el Imperial College London.
Las cuatro letras de las bases del ADN —A, T, C y G— se convierten en 01, 00, 11 y 10. “Luego sintetizas una molécula -la representación física real de esos datos- y la almacenas durante el tiempo que quieras”.
La frase favorita entre los investigadores del almacenamiento de datos en ADN es que “podrías guardar todos los datos del mundo en una cucharadita”, comenta Heinis. En la práctica, sin embargo, sería muy difícil localizar la información que buscas dentro de esa masa indiferenciada, señala.
Lo fundamental es que los requisitos de almacenamiento no son intensivos en energía. “Es eficiente desde el punto de vista energético, porque si lo guardas en un lugar adecuado, no necesitas refrigerarlo en absoluto”, explica Heinis.
Eestán empezando a surgir startups en el ámbito del almacenamiento en ADN y en los últimos años se ha avanzado en reducir el coste de “leer” ADN, señala Heinis. Pero el coste total es un obstáculo.
“Sigue siendo demasiado caro”, afirma, especialmente en lo que respecta a la síntesis del ADN. “En la parte de ‘escritura’ aún no hemos visto un gran avance, así que eso es lo que realmente tiene que ocurrir”, dice Heinis. “Una vez que sea lo suficientemente barato, todo lo demás encajará”.
Aunque Heinis describe los cristales de memoria de Kazansky como un “competidor directo del almacenamiento en ADN”, donde el ADN podría tener ventaja es en que “siempre podremos leer ADN”, debido a sus amplias aplicaciones médicas.
“Con otras tecnologías, la pregunta es cuánto tiempo existirá el dispositivo de lectura”, afirma.
Heinis señala que hoy es cada vez más difícil leer soportes como los disquetes, que aparecieron en los años 70 pero quedaron prácticamente obsoletos a comienzos de los 2000. “Hay empresas que ofrecen almacenamiento de datos por más de 100 años. Pero ¿cuáles de esas empresas seguirán existiendo dentro de 100 años?”, pregunta.
Entre los gigantes tecnológicos, Microsoft es quien ha mostrado mayor interés en experimentar con nuevos tipos de almacenamiento. En 2016, la compañía anunció que había almacenado 200 MB de datos en ADN, incluyendo una base de datos de semillas del Svalbard Global Seed Vault y la Declaración Universal de los Derechos Humanos en más de 100 idiomas.
En 2020, Microsoft y otras empresas fundaron la DNA Data Storage Alliance (Alianza de Almacenamiento de Datos en ADN).
“La demanda de almacenamiento de datos a largo plazo en la nube está alcanzando niveles sin precedentes, y estamos llegando al límite de lo posible con las tecnologías actuales”, dijo un portavoz de Microsoft a la BBC.
Microsoft también patrocinó al grupo de investigación de Kazansky en la Universidad de Southampton como parte de Project Silica entre 2017 y 2019. “Demostramos juntos el principio fundamental; después de eso, ellos continuaron desarrollando la tecnología de manera independiente”, afirma Kazansky.
En febrero de 2026, Microsoft publicó un artículo en Nature detallando un nuevo avance en este campo. La empresa logró almacenar datos en vidrio de borosilicato, el mismo que se utiliza en utensilios de cocina y puertas de hornos, además del vidrio estándar de sílice fundida.
El vidrio de borosilicato es mucho más barato -lo que hace que la idea sea más viable económicamente- y también muy duradero. La compañía afirma que estos datos podrían almacenarse hasta 10.000 años.
Microsoft indicó a la BBC que, aunque sus pruebas de concepto han mostrado resultados prometedores, por ahora no está comercializando esta línea de investigación.

Repensar la computación
Resolver el problema del almacenamiento de datos a largo plazo es solo una parte del desafío que representan los centros de datos, grandes consumidores de energía.
La sílice y el ADN son “muy atractivos desde una perspectiva de sostenibilidad”, reconoce Tania Malik, profesora adjunta en la Escuela de Computación y Ciberseguridad de la Universidad Tecnológica de Dublín (Irlanda).
“Sin embargo, es poco probable que estas tecnologías sustituyan al almacenamiento convencional para la informática cotidiana o las cargas de trabajo de IA en un futuro cercano”, advierte.
Malik señala que existen formas más prácticas de abordar, en el corto plazo, el problema del consumo energético asociado a los “datos calientes”.
“Un área importante es mejorar la eficiencia de la infraestructura, por ejemplo mediante procesadores más eficientes energéticamente y técnicas avanzadas de refrigeración, como la refrigeración líquida o la refrigeración por aire exterior”, afirma.
Al mismo tiempo, añade que hay un “reconocimiento creciente de que la eficiencia también debe abordarse a nivel del software y de las cargas de trabajo, no solo a nivel de la infraestructura”.
Malik afirma que en la informática de alto rendimiento y en la computación en la nube, el rendimiento ha sido tradicionalmente la métrica dominante, pero la eficiencia energética debe considerarse igual de importante. “Esto implica diseñar algoritmos y aplicaciones que sean conscientes del consumo de energía”.
Añade que esto también implica usar la cantidad adecuada de potencia de cómputo para cada tarea. “No todas las tareas necesitan el modelo de IA más grande posible ni el tiempo de ejecución más rápido”, apunta.
Pero, frente a la acumulación exponencial de datos, puede que también se requiera un replanteamiento más radical, señala Malik. ¿Realmente necesitamos todos los datos que producimos? Cada vez más, parte de la solución, dice, consiste en “ser más intencionales con lo que elegimos conservar”.
Haz clic aquí para leer más historias de BBC News Mundo.
Suscríbete aquí a nuestro nuevo newsletter para recibir cada viernes una selección de nuestro mejor contenido de la semana.
También puedes seguirnos en YouTube, Instagram, TikTok, X, Facebook y en nuestro nuevo canal de WhatsApp.
Y recuerda que puedes recibir notificaciones en nuestra app. Descarga la última versión y actívalas.



